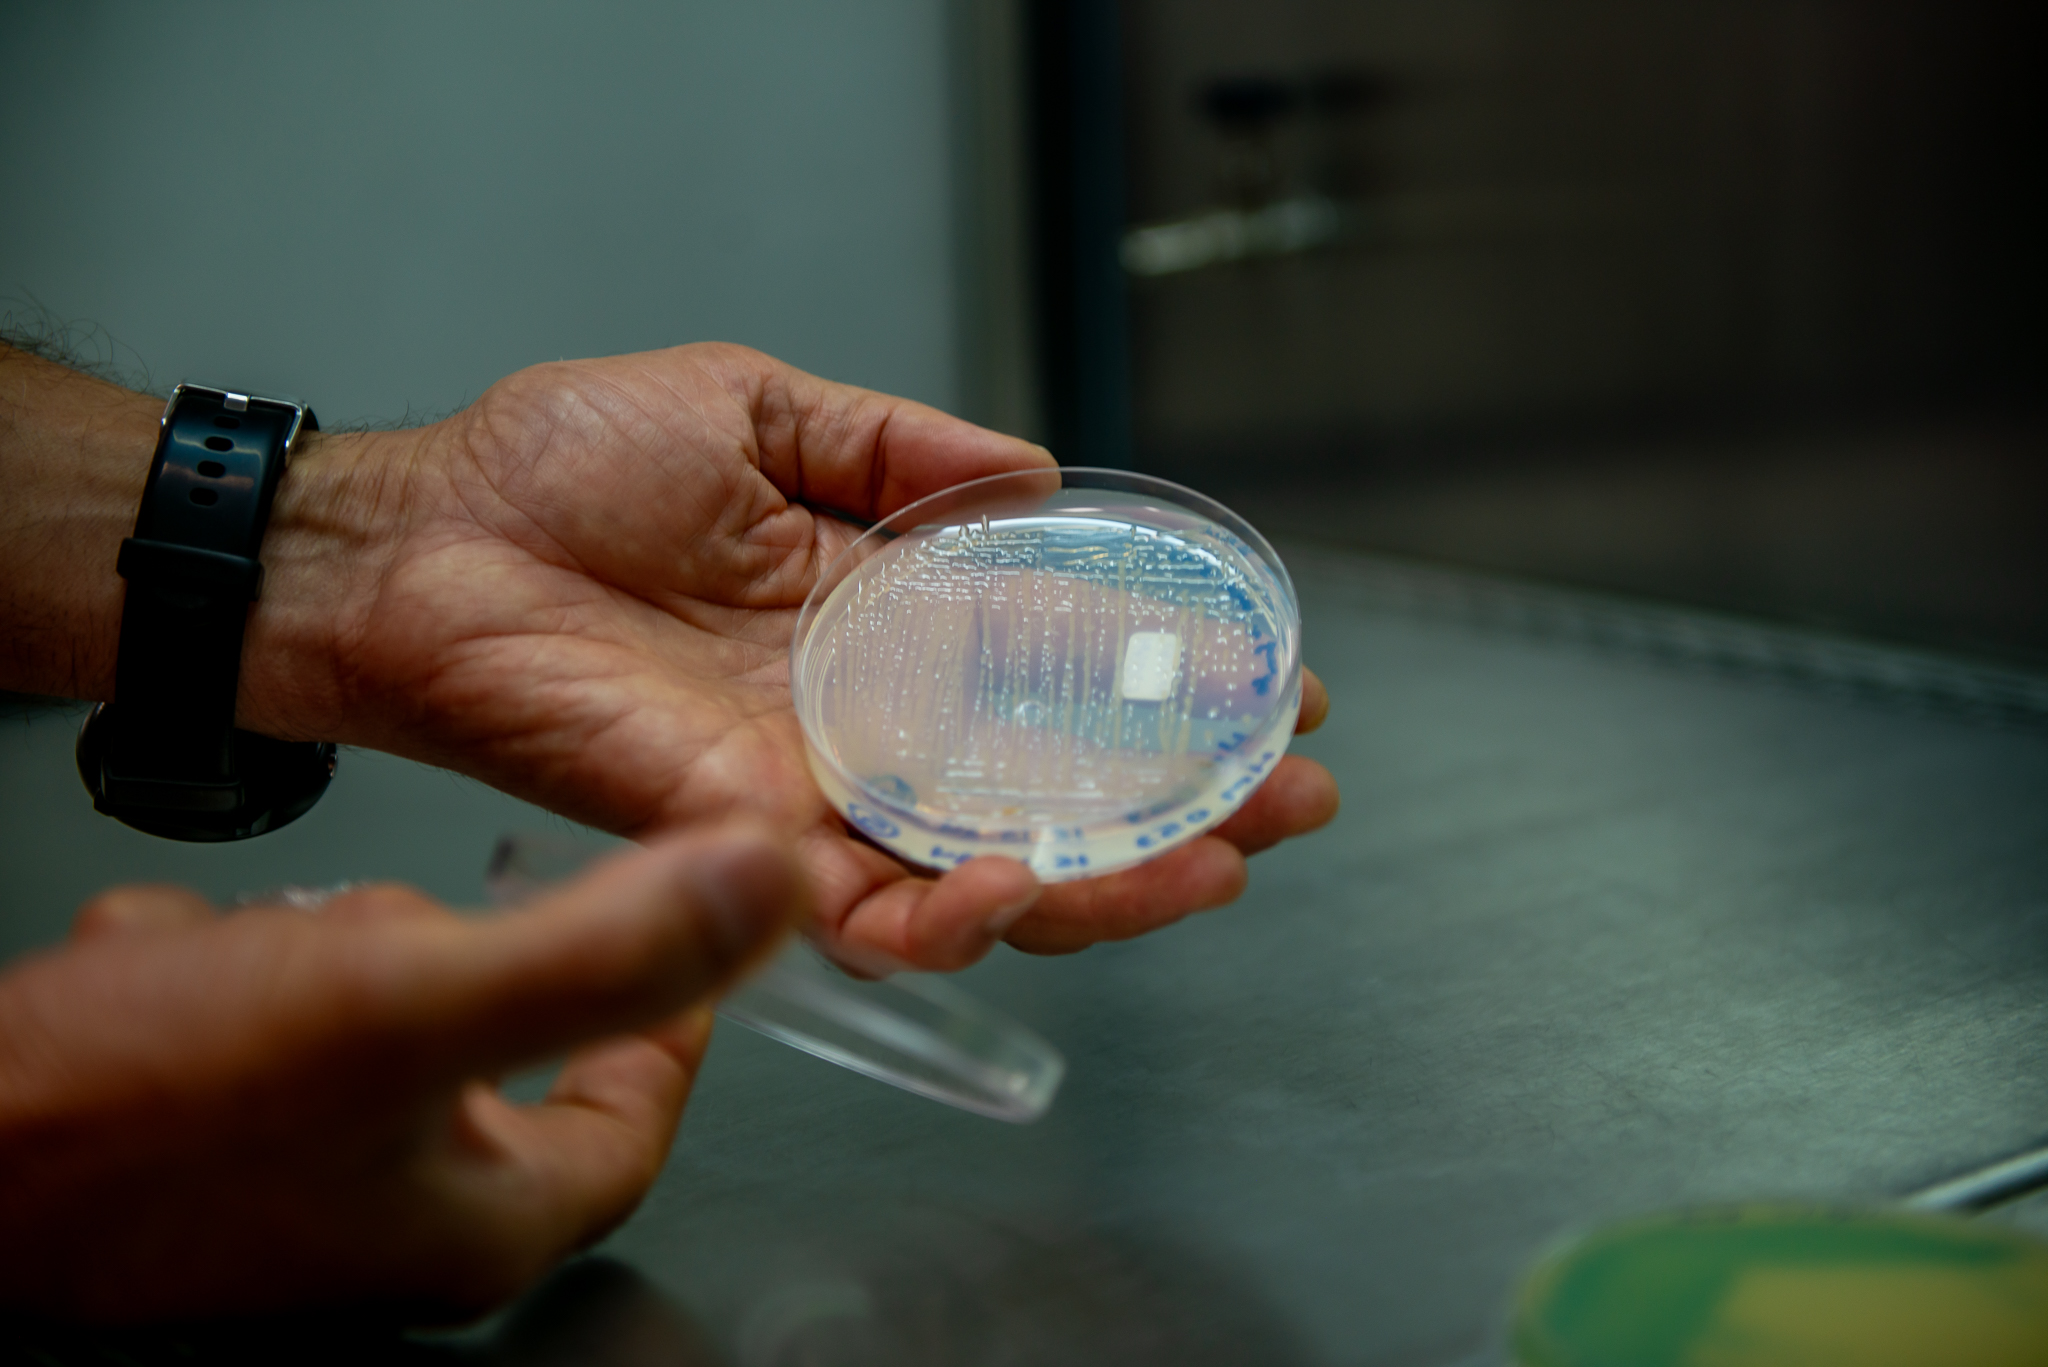

Publicado originalmente em Ciência UFPR por Jéssica Tokarski. Para acessar, clique aqui.
A partir do aprimoramento de microrganismo que coloniza raízes de plantas e tem alta capacidade de fixar nitrogênio, pesquisadores em Bioquímica da UFPR trabalharam décadas para criar inoculante que alavanca produção na agricultura
Bactérias fixadoras de nitrogênio são microrganismos encontrados naturalmente em raízes de plantas como milho, trigo, cana-de-açúcar e arroz. Seu papel de fixar nitrogênio e liberá-lo para a planta permite a redução do uso de fertilizantes, um dos insumos mais caros na agricultura. Ainda que descobertas há cerca de 130 anos, estudos recentes têm ampliado as possibilidades de sua utilização e aprimorado seu desempenho.
É o caso da bactéria HM053, uma cepa que pertence à espécie Azospirillum brasilense, que foi selecionada pelo professor do Programa de Pós-Graduação em Bioquímica da Universidade Federal do Paraná (UFPR), Fábio de Oliveira Pedrosa, e seu então aluno de mestrado, Hidevaldo Bueno Machado.
Isso ocorreu em 1987, no Núcleo de Fixação Biológica de Nitrogênio, por uma técnica chamada evolução adaptativa. Essa estirpe tem uma capacidade de fixar nitrogênio aumentada muitas vezes em decorrência do processo de seleção.

“A partir do isolamento e da caracterização de mutantes de Azospirillum brasilense resistentes a etilenodiamina, selecionamos quatro estirpes para caracterização bioquímica, fisiológica e genética. Todas foram capazes de fixar nitrogênio”, pontua Pedrosa.
Esse processo levou em torno de dois anos, considerando todas as etapas pelas quais o experimento passou. Para isso, a bactéria parental, chamada de “mãe”, foi colocada em condições nas quais precisou se ajustar para sobreviver. Tais condições permitiram a seleção de bactérias “filhas”, com características otimizadas.
“Foram usadas três condições distintas para identificar qual seria capaz de selecionar a melhor bactéria. A partir dessas três condições, foram isoladas cerca de 600 bactérias ‘filhas’ e cada um delas passou por uma bateria de vários testes para identificarmos as melhores. Dessas ‘filhas’, quatro foram selecionadas, e, das quatro, elegemos a HM053 por produzir grande quantidade de amônia”, explica Emanuel Maltempi de Souza, professor do Departamento de Bioquímica e Biologia Molecular da UFPR e cientista do Núcleo de Fixação Biológica de Nitrogênio da UFPR.
Depois do sequenciamento do genoma da HM053 e de várias análises, os cerca de 20 pesquisadores da UFPR que, de alguma forma, contribuíram com o estudo, identificaram a mudança genômica que levou ao fenótipo único dessa bactéria. Souza conta que apenas duas décadas depois é que foram compreender melhor as novas características da bactéria.
“Hoje entendemos bem o que está ocorrendo e temos condições inclusive de melhorar ainda mais suas características. Isso sem a produção de bactérias transgênicas, mas utilizando técnicas clássicas e edição gênica”.
Experimentos apontaram que além do alto potencial de fixação de nitrogênio, a HM053 tem capacidade aumentada de produzir compostos estimulantes do crescimento vegetal, ou seja, fitormônios.
“Deste modo, a bactéria estimula o crescimento e o desenvolvimento da planta, além de fornecer a ela um nutriente essencial. Como contrapartida, a planta libera exsudatos, uma mistura de compostos que incluem nutrientes e outras substâncias benéficas para a bactéria”, esclarece o estudioso.
Segundo o professor, testes em campo em associação com outros cientistas comprovaram que a HM053 aumentou a produtividade de milho em até 28%.
“Salientamos que as condições de campo são muito mais complexas e variáveis do que as do laboratório, portanto é possível que outros fatores que ainda não avaliamos sejam importantes para o efeito observado na produtividade”, revela.
Parceria com empresa viabilizou colocar produto no mercado
Recentemente a UFPR firmou parceria com a empresa Bioma, que desenvolve soluções tecnológicas na linha de inoculantes e fertilizantes, para que a HM053 e outras duas novas estirpes fossem testadas em condições de campo na cultura de milho, com uma formulação industrial própria.
“Os resultados da Bioma confirmaram o que nós e nossos colaboradores havíamos observado e permitiu que a empresa solicitasse autorização ao Ministério da Agricultura e Pecuária (Mapa) para uso comercial do novo inoculante”, comenta Souza.
A Bioma utiliza a bactéria HM053 na sua fórmula de inoculante, um líquido que tem, além da bactéria em suspensão, uma série de aditivos importantes de propriedade intelectual da empresa. O inoculante é aplicado sobre a semente antes do plantio e, quando ela germina, a bactéria se prolifera à medida que o sistema radicular se desenvolve.

 Colônia de bactéria A. brasilense em foto de microscopia. Foto: H.J.O. Ramos et al./Reprodução
Colônia de bactéria A. brasilense em foto de microscopia. Foto: H.J.O. Ramos et al./Reprodução“Acreditamos que ocorra uma espécie de ciclo virtuoso: a bactéria estimula o crescimento das raízes pela liberação de amônia e bioestimulantes, enquanto o sistema radicular mais robusto libera mais nutrientes para bactéria, que se multiplica e aumenta liberação de amônia e bioestimulantes”, esclarece o professor.
De acordo com Márcio Araújo, diretor comercial da Bioma, a companhia estabeleceu um processo de produção e formulação inovadoras da estirpe, conferindo à tecnologia — nomeada Bioma Mais Energy — maior resistência, concentração e viabilidade de células, resultando em um produto de alta performance.
“Com o pioneirismo do registro no Mapa para a cultura do milho, o lançamento da Bioma demonstrará que os testes da pesquisa são replicáveis e que a inovação pode aumentar a lucratividade dos produtores, contribuindo com a economia nacional”.
“A aprovação dessas estirpes para uso como inoculante é mais uma grande vitória do trabalho que temos realizado no Núcleo de Fixação de Nitrogênio. Elas se juntam às estirpes de Azospirillum brasilense FP2 e FP10 (conhecidas comercialmente por Ab-V5 e Ab-V6, respectivamente), construídas por nós, que hoje já são largamente utilizadas na agricultura brasileira como inoculante de gramíneas e como co-inoculante na cultura de soja”, comemora Pedrosa.
Perspectivas de aumento na produtividade agrícola
De acordo com os resultados dos estudos feitos em parceria com a empresa, o principal benefício da utilização da fórmula é o aumento da produtividade.
A partir de cálculos conservadores, os pesquisadores consideram um incremento mínimo de 10% na cultura de milho, o que representaria um aumento de aproximadamente R$ 10 bilhões no valor total da safra de 2023, estimada em R$ 101,8 bilhões pelo Instituto Brasileiro de Geografia e Estatística (IBGE).
“A tecnologia é extremamente acessível, desenvolvida por pesquisadores e pela indústria nacional, garantindo um retorno excepcional para o agricultor. Além disso, observamos ainda que a inoculação traz outros benefícios, como sistema radicular mais desenvolvido; melhor uso de nutrientes do solo pela planta; maior resistência da planta a pragas e, principalmente, maior resistência a períodos secos”, afirma Souza.

 Cepas de bactérias da Azospirillum brasilense são testadas em lavouras de milho desde os anos 1970 para substituir fertilizantes nitrogenado. Foto: Dênio Simões/Agência Brasília
Cepas de bactérias da Azospirillum brasilense são testadas em lavouras de milho desde os anos 1970 para substituir fertilizantes nitrogenado. Foto: Dênio Simões/Agência BrasíliaTestes com a HM053 já foram realizados e tiveram sucesso em outras culturas, como trigo e morangos. Resultados excelentes na co-inoculação de soja com a HM053 e com outra bactéria selecionada pela UFPR, a HM210, também foram obtidos em condição de campo.
“Embora nossos resultados indiquem que as bactérias estimulam crescimento de outras culturas, somente a testagem em condições de campo sob protocolos rígidos pode realmente comprovar o efeito”, alerta o especialista.
Caminhos tecnológicos para produtos nacionais e sustentáveis
O objetivo dos pesquisadores da universidade é compreender a fixação biológica de nitrogênio em bactérias associativas; como essa interação entre planta e bactéria é estabelecida; como a planta reconhece que a bactéria não é patogênica; e quais funções cada uma exerce nessa parceria.
Com os resultados desses estudos, foi possível apontar o caminho para a indústria desenvolver uma nova tecnologia com grande potencial e que gerará royalties para a instituição.
Um dos grandes diferenciais dessa inovação é a sustentabilidade, pois, além de ser um produto natural, tem o potencial de reduzir a utilização de fertilizantes químicos nitrogenados (como nitrato, amônio e ureia). Esses fertilizantes, além de muito caros, são facilmente perdidos com as águas das chuvas, que os arrastam para mananciais e lençóis freáticos, causando poluição e ameaçando a saúde humana e animal e o meio ambiente.
A produção de fertilizantes químicos também gera um grande passivo ambiental devido à emissão de gases de efeito estufa: 2% da demanda global de energia fóssil (óleo combustível, diesel e gás natural) é destinada à produção e ao transporte de fertilizantes nitrogenados. Além disso, a escala necessária para essa atividade faz com que esse setor seja altamente concentrado em grandes grupos empresariais, sendo que 70% da produção mundial é concentrada em apenas dez empresas.
A solução desenvolvida pela UFPR e seus parceiros, além de sustentável, fortalece o mercado nacional, pois se trata de um produto totalmente brasileiro, desde a tecnologia até a produção, eliminando a necessidade de importações e intermediários externos e fomentando a indústria e as cadeias produtivas nacionais.
“A ciência não pode parar; novas tecnologias dependem de novas descobertas”, diz Souza.